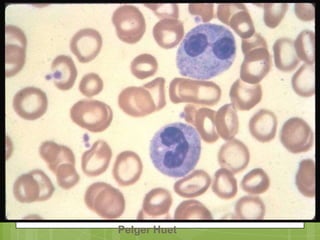
Pelger Huet
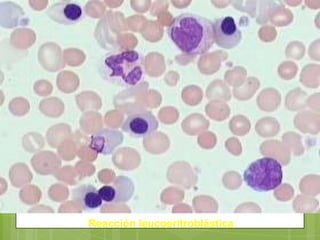
Reacción leucoeritroblástica

Este documento describe las principales alteraciones que pueden presentarse en un frotis de sangre periférica. Explica las alteraciones en el tamaño, color y forma de los eritrocitos, así como las inclusiones eritrocitarias. También describe las alteraciones leucocitarias más comunes como leucocitosis, neutrofilias, reacción leucemoide, leucopenias y alteraciones en los niveles de linfocitos, eosinófilos, monocitos y basófilos. Por último, detalla algunas anomalías que pueden presentarse en el nú